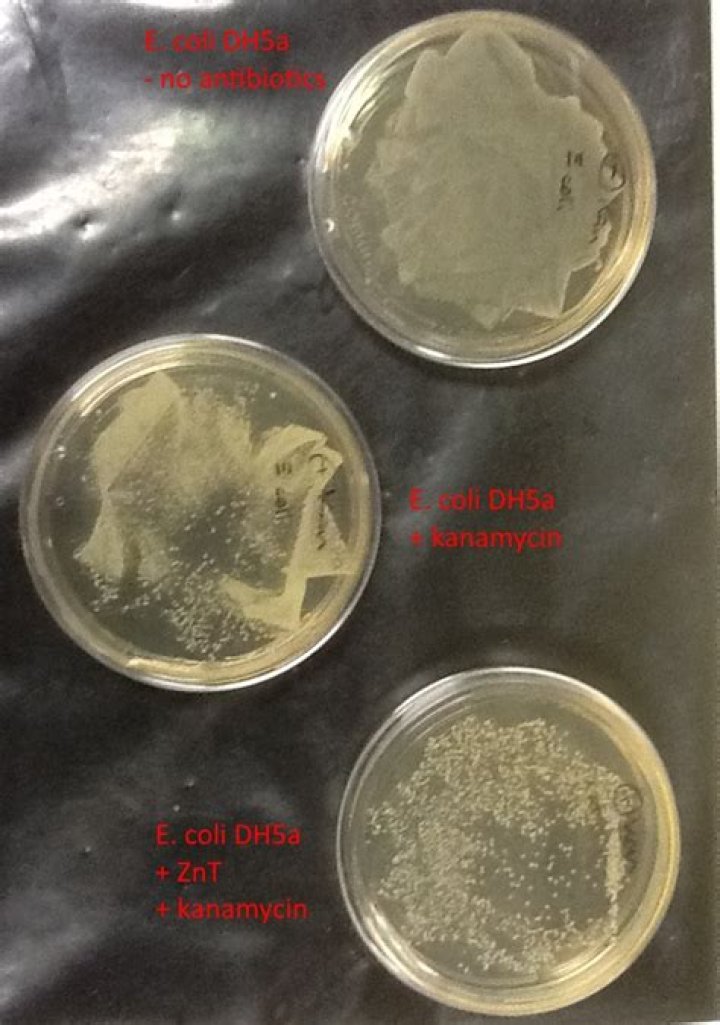

Is e coli resistant to kanamycin?
 Andrew Vasquez
Andrew Vasquez
In addition, the kanMX marker renders E. coli resistant to kanamycin.
Is E. coli susceptible to kanamycin?
coli strains isolated from well neonates, well pediatric outpatients, and ill neonates were determined, and the incidence of antibiotic-resistant strains was correlated with epidemiologic data. Ninety-five per cent of these isolates were susceptible to kanamycin and 98 per cent to gentamicin.
Is kanamycin effective against E. coli?
The aminoglycoside antibiotic kanamycin damages DNA bases in Escherichia coli: caffeine potentiates the DNA-damaging effects of kanamycin while suppressing cell killing by ciprofloxacin in Escherichia coli and Bacillus anthracis. Antimicrob Agents Chemother.
What is resistant to kanamycin?
griseus ISP5236, which produce kanamycin, neomycin or streptomycin respectively, were highly resistant to the antibiotics they produced. Polyphenylalanine synthesis in cell free systems was also resistant to the action of the antibiotics.
Which antibiotic is E. coli most resistant to?
From 50 tested E. coli isolates, all of them (100%) were resistant to penicillin and erythromycin, followed by 49 (98%) to nalidixic acid, 47 (94%) to cephalexin, 43 (86%) to amoxicillin, 42 (84%) to ampicillin, 37 (74%) to ciprofloxacin, 32 (64%) to tetracycline, 27 (54%) to cefixime and 18 (36%) to gentamicin.
Microbiology - Bacteria Antibiotic Resistance
16 related questions foundWhich drugs are E. coli resistant to?
coli isolates showed an increasing resistance trend to 11 antimicrobial agents (ampicillin, sulfonamide, tetracycline, cephalothin, trimethoprim/sulfamethoxazole, streptomycin, chloramphenicol, cefoxitin, gentamicin, amoxicillin/clavulanic acid, and kanamycin), and human E.
What drug is resistant to E. coli?
There was a wide range of resistance of the E. coli isolates [Figure 1] to all the commonly used antibiotics in this environment, namely, amoxicillin, gentamicin, cotrimoxazole, augmentin, ciprofloxacin, norfloxacin, streptomycin and nalidixic acid. The result also showed a higher level of resistance of E.
How does kanamycin affect target bacteria?
Kanamycin is an aminoglycoside antibiotic. Aminoglycosides work by binding to the bacterial 30S ribosomal subunit, causing misreading of t-RNA, leaving the bacterium unable to synthesize proteins vital to its growth.
What is the difference between kanamycin A and kanamycin B?
Kanamycin A has a hydroxy group at position C2′, whereas kanamycin B possesses an amino group at this position (Fig 1B). Their specific interactions with bacterial ribosomal RNAs to inhibit bacterial protein synthesis have been clearly observed through X-ray structural analysis [2].
What class of antibiotic is kanamycin?
Kanamycin belongs to the class of medicines known as aminoglycoside antibiotics. It works by killing bacteria or preventing their growth.
How does kanamycin resistance gene work?
Mechanism. Kanamycin works by interfering with protein synthesis. It binds to the 30S subunit of the bacterial ribosome. This results in incorrect alignment with the mRNA and eventually leads to a misread that causes the wrong amino acid to be placed into the peptide.
Is gentamicin the same as kanamycin?
Since kanamycin appeared less bactericidal in vivo, it may produce less bacteriolysis with lesser amounts of endotoxin, resulting in lower incidence of early death, whereas gentamicin is more bactericidal in vivo and may release larger amounts of endotoxin, leading to higher incidence of early death.
What is the generic name of kanamycin?
Kantrex (kanamycin) Injection is an aminoglycoside antibiotic used to treat serious infections caused by bacteria.
Is kanamycin broad or narrow spectrum?
The aminoglycosides, which include drugs such as streptomycin, gentamicin, neomycin, and kanamycin, are potent broad-spectrum antibacterials.
Is kanamycin used for Gram positive or negative?
Kanamycin A is similar to streptomycin and neomycines, and it possesses a broad spectrum of antimicrobial action. It is active with respect to most Gram-positive and Gram-negative microorganisms (staphylococci, colon bacillus, klebisella, Fridlender's bacillus, proteus, shigella, salmonella).
Is kanamycin bacteriostatic or bactericidal?
Both kanamycin (t½ 2–4 h) and amikacin (t½ 2–4 h) are bactericidal drugs of the aminoglycoside class, valuable in patients with resistance to streptomycin.
What is kanamycin effective against?
Kanamycin, an aminoglycoside, acts by inhibiting the synthesis of protein in susceptible microorganisms. It is bactericidal in vitro against Gram-negative bacteria and certain Gram-positive bacteria. Mechanism of Resistance. Aminoglycosides are known to be ineffective against Salmonella and Shigella species in patients ...
Are kanamycin and neomycin the same?
In general, neomycin is used in experiments on prokaryotic cells, while G418 is used in eukaryotic experiments. Kanamycin is an aminoglycoside antibiotic that functions by inhibiting translocation of the ribosome which leads to mistranslation.
What is the mode of action for kanamycin?
Basic biology information Drug target/mechanism: Kanamycin (KAN) is an aminoglycoside antibiotic having the same mode of action as streptomycin (STR); it inhibits protein synthesis by tightly binding to the conserved A site of 16S rRNA in the 30S ribosomal subunit.
How kanamycin A interacts with bacterial and mammalian mimetic membranes?
Kanamycin A belongs to the family of aminoglycoside antibiotics that target cellular RNA to inhibit bacterial and viral replication. Previous studies have shown that aminoglycosides bind to mammalian but disrupt bacterial membranes. ... This indicates the bacterial membrane disruption observed by previous studies.
What is the purpose of the kanamycin resistance cassette?
Compared to the widely used ermF-ermAM cassette, the kanamycin cassette used in the transformation experiments gave rise to additional antibiotic-resistant T. denticola colonies. The kanamycin cassette is effective for allelic replacement mutagenesis as demonstrated by inactivation of two open reading frames of T.
Is E. coli resistant to Augmentin?
Augmentin resistance was approximately comparable among E. coli isolates from male (14.29%) and female (13.79%) and the highest (27.27, and 15.78%) among patients more than 65 years old and equal or less than 6 years old respectively.
Is E. coli resistant to Sulphatriad?
The isolates showed single, double, and triple antibiotic resistance. Fifty-three percent of them were resistant to cephalothin. Resistance was also recorded for sulphatriad (33%), colistin sulphate (26%), streptomycin (0.7%), and tetracycline (26%).
Why is E. coli drug resistant?
When E. coli infections don't respond to other antibiotic drugs, doctors may reach for a last-resort option known as colistin. But in recent years, some strains of E. coli and other bacteria have developed resistance to colistin, thanks to the spread of an antibiotic-resistance gene known as mcr-1.



